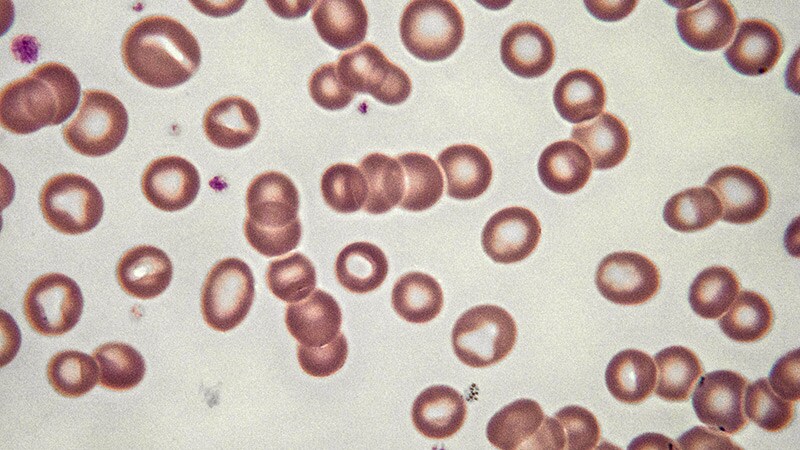

Orthopedics
UK News & Perspectives View All
Featured Orthopedics News & Perspectives
Latest News View All
-
Explainer-What Other Health Conditions Might Weight-loss Drugs Treat?
-
 Hospital Adverse Events Rise Post Private Equity Acquisition
Hospital Adverse Events Rise Post Private Equity Acquisition -
 ECG Deep-Learning Algorithm Predicts Mortality Post Surgery
ECG Deep-Learning Algorithm Predicts Mortality Post Surgery -
 Infections Down in Acute Care Hospitals
Infections Down in Acute Care Hospitals -
 Debate Grows Over Facility Fees, Lawmakers Urge Transparency
Debate Grows Over Facility Fees, Lawmakers Urge Transparency -
 Top 10 Fictional Docs on Streaming TV
Top 10 Fictional Docs on Streaming TV -
 Bimekizumab Promising for Palmoplantar Pustular Psoriasis
Bimekizumab Promising for Palmoplantar Pustular Psoriasis -
 Antiobesity Drugs in OA: Slow, Moderate Approach Deemed Best
Antiobesity Drugs in OA: Slow, Moderate Approach Deemed Best
Trending With Orthopedists
Perspectives View All
Columnists
Journal Articles View All
-
Hypoalbuminemia as a Predictor of Mortality in Spine Surgery
-
Updates in the Early Management of Acute Spinal Cord Injury
-
Scoliosis Screening Using a Bodysuit and 3D Imaging
-
Preoperative Symptom Duration and Lumbar Discectomy Outcomes
-
Augmented Reality Applications in Orthopedic Spine Surgery
-
Review of Multidirectional Instability of the Shoulder